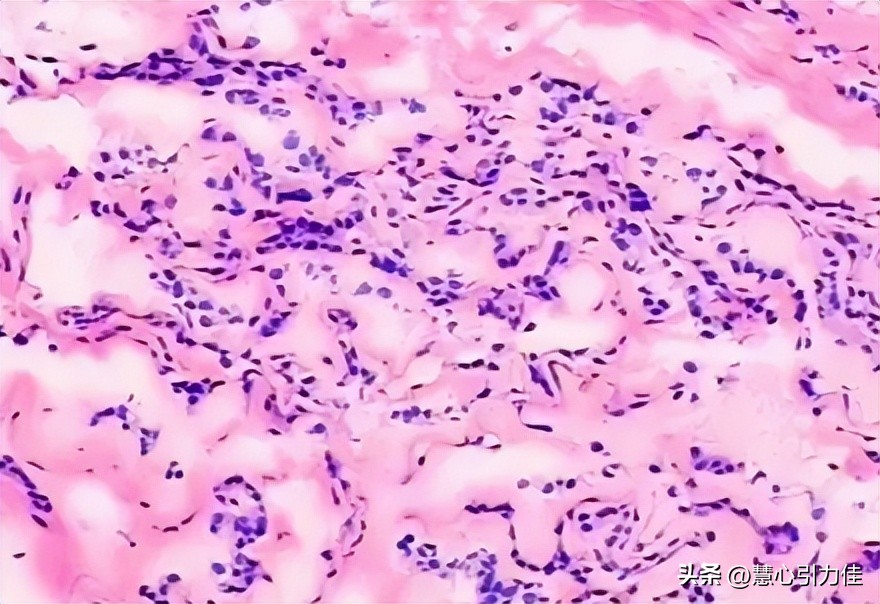
制样方法对IF钢透射电镜复型样品分析,样品的表面光洁度有何变化

随着材料科学与工程的发展,透射电镜成为研究材料微结构和相变行为的重要工具,IF钢作为一种重要的工业材料,其微观结构对其性能和性质具有重要影响,因此,对IF钢的透射电镜复型样品进行分析,评估不同制样方法对结果的影响,具有重要的理论和实际意义,本文旨在探讨制样方法对IF钢透射电镜复型样品分析的影响,并提出一种较为准确和可靠的制样方法,为IF钢的透射电镜研究提供参考。

一、传统切片制样方法
1. 切片制备工艺
切片制备工艺是一种常用的透射电镜样品制备方法,该方法起源于20世纪初,当时的科学家们迫切需要一种能够观察材料内部结构的方法,切片制备工艺在材料科学领域发展至今已有悠久的历史,并经过多年的改进和优化。
切片制备的过程通常包括以下几个主要步骤,首先,需要选择合适的材料样品,并进行初步处理,以确保样品的表面光洁度和尺寸适宜,其次,使用一台高精度的切片机器,将样品切割成非常薄的薄片,切片的厚度通常在几十到几百纳米之间,这要求切片机器具备高精度和稳定的切割能力。

切割完成后,需要对切片进行必要的修整和处理,这包括使用显微镜观察切片的表面和边缘,确保其光滑和无明显损伤,如果切片表面存在污染或氧化层,还需要进行清洗和去除处理,以保证样品的纯净性和可观测性。
为了提高切片的质量和稳定性,科学家们还开发了一系列辅助技术和工艺,例如,在切片过程中可以利用冷却液或者液氮来降低样品的温度,以减少热膨胀对切割的影响,此外,还可以使用特殊的刀片材料和几何形状,以实现更精细和准确的切割。
切片制备工艺具有一定的优点和局限性, 首先,切片制备相对简单直观,可以应用于各种材料样品,包括金属、陶瓷、聚合物等 ,其次,切片制备的样品尺寸较小,适合透射电镜观察,可以提供高分辨率的显微结构信息,然而,切片制备也存在一些挑战和限制,如样品的薄度控制、切割过程中的破损风险以及切片表面的平整度等方面。

2. 切片制备的优点和缺点
切片制备是一种常用的制样方法,广泛应用于材料科学领域的透射电镜分析,它的优点在于简单易操作、成本较低,同时具有一定的历史依据,首次引入切片制备技术可以追溯到19世纪,当时科学家们开始使用机械切割工具将材料切割成薄片进行观察和分析。
切片制备的主要优点之一是制备过程相对简单,它不需要复杂的仪器设备或高级技术,通常可以在实验室中进行操作,对于一些常见的材料,制备过程非常熟悉和标准化,操作人员可以轻松掌握并获得可重复的结果,这种简单性使得切片制备成为透射电镜分析中的常用方法之一。
此外,切片制备的成本较低,相对于其他一些复杂的制备方法来说更为经济实惠,材料切割工具和所需的切片材料相对便宜,并且可以多次使用,这使得切片制备成为大规模样品分析和批量制备的首选方法。

然而,切片制备也存在一些局限性和缺点,首先,由于切片制备是一种物理性的切割过程,它在一定程度上会引入机械应力和热应力,可能导致样品的形变、位错或晶体缺陷的产生,这些不可避免的缺陷可能会对透射电镜观察和分析产生一定的干扰,限制了对材料真实微观结构的准确理解。
其次,切片制备的薄片厚度通常较大,难以满足对于高分辨率观察和分析的要求,尽管切片工具可以制备相对较薄的切片,但通常难以获得高于几十纳米的厚度,这对于一些纳米材料或需要更高分辨率的研究来说是一个挑战。
此外,切片制备的样品通常需要进行后续的处理和制备步骤,如薄化、离子清理等,以满足透射电镜观察的要求,这增加了制备的复杂性和时间成本,并且可能引入额外的误差。

二、离子薄化制样方法
1. 离子薄化工艺
离子薄化工艺是一种用于透射电镜样品制备的重要方法,该工艺的发展可以追溯到20世纪50年代,当时科学家们开始尝试使用离子束来加工和修复材料表面,随着电子显微镜技术的迅速发展,离子薄化工艺也逐渐应用于透射电镜样品的制备中。
离子薄化工艺的基本原理是利用离子束对样品表面进行加工和剥离,形成较薄的透射电镜样品,该工艺涉及到三个主要步骤:准备、薄化和清洗。
在准备阶段,需要将待制备的样品固定在样品台上,并进行表面的清洁处理,这一步骤的目的是去除可能存在的污染物和氧化层,以确保样品表面的纯净度和平整度。

接下来是薄化阶段,主要是通过离子束轰击样品表面来使其逐渐减薄,离子束的选择取决于样品的性质和要求,常用的离子种类包括氩离子、氮离子和氖离子等,离子束的能量和注入量也需要根据样品的材料特性进行调节,离子束轰击样品表面后,样品的原子将受到离子束的能量影响而逐渐剥离,从而形成较薄的样品。
最后是清洗阶段,目的是去除离子薄化过程中产生的残留物和污染物,清洗方法通常涉及溶剂浸泡、超声清洗和高压气体喷射等,清洗的目的是使样品表面干净、平整,以提供良好的观察条件和可靠的实验结果。
离子薄化工艺在透射电镜样品制备中具有许多优点,首先,它可以制备出非常薄的样品,提供更好的透射电镜分辨率和观察效果,其次,离子薄化过程对样品的化学成分和晶体结构影响较小,减少了样品的形变和伪相现象,此外,离子薄化还可以实现对特定区域的定点加工,使得研究者能够选择感兴趣的区域进行分析。

2.离子薄化的优点和缺点
离子薄化作为一种常用的制样方法,具有其独特的优点和一些局限性,首先,我们将详细介绍离子薄化的优点。
离子薄化的首要优点在于其高度精确的制备能力,离子薄化技术可以通过控制离子束的能量和角度,实现对材料样品的准确削薄,这种精确的削薄过程能够产生均匀的样品表面,减少样品的表面粗糙度和晶格变形,同时, 离子薄化能够实现对样品的局部削薄,从而在感兴趣的区域提供更高的分辨率,有助于研究微观结构和相变行为 。
其次,离子薄化具有较高的剥离效率和样品损伤较小的特点,离子束在样品表面的相互作用下,能够将材料原子或分子剥离,使得样品的厚度减小,与传统切片制样方法相比,离子薄化不需要机械切割,因此减少了样品的机械应力和损伤,这种非接触式的制样方法可以更好地保留样品的原始结构和化学组成,提供更真实、准确的样品形貌信息。

此外,离子薄化还具有一定的制备速度和灵活性,离子束在材料表面作用的过程相对较快,因此离子薄化方法能够在相对短的时间内获得薄片,另外,通过调整离子束的能量和角度,可以根据不同的研究需求制备不同厚度的薄片,满足实验的需要。
然而,离子薄化也存在一些局限性和缺点,首先,离子薄化技术的设备和操作相对复杂,需要专业的设备和熟练的操作技能,此外, 离子束在与样品相互作用时,会产生热量和电荷效应,可能引起样品的局部加热和损伤 ,因此,在进行离子薄化时需要仔细选择合适的离子束参数和制样条件,以避免样品的进一步损伤。

三、高压冷冻切片制样方法
1. 高压冷冻切片制备工艺
高压冷冻切片制备工艺是一种常用于透射电镜样品制备的先进方法,其历史可以追溯到20世纪70年代,当时科学家们意识到传统制备方法在观察高分辨率样品时存在一些困难,为了解决这个问题,研究人员开始尝试使用高压冷冻切片技术。
高压冷冻切片制备工艺的基本原理是在极低温和高压的环境下将样品快速冷冻,使其保持原有的水合状态,并防止溶质的析出,这种冷冻方式可以防止晶格破坏、结构变形以及一些生物样品的变性,此外,高压冷冻切片还能够减少溶剂的挥发和样品中溶质的扩散,从而保持样品的原始形态和结构。

具体的制备步骤包括以下几个关键步骤:首先,将待制备的样品放置在高压冷冻仪器中,然后,通过控制仪器的温度和压力,将样品迅速冷冻至非常低的温度,通常在液氮温度以下,在高压的作用下,样品的水分子形成冰晶,保持了样品的原始状态,接下来,冷冻的样品通过切片机械进行切割,获得薄片样品,这些薄片样品可以通过透射电镜进行观察和分析。
高压冷冻切片制备工艺的优点是能够在较短的时间内获得高质量的样品,并且保持了样品的原始结构和形态,与传统制备方法相比,它可以有效地减少样品的伪装和变形,提供更准确的微观结构信息,因此,高压冷冻切片制备工艺在材料科学、生物学和医学等领域得到了广泛的应用。
总之,高压冷冻切片制备工艺是一种重要的透射电镜样品制备方法,通过控制温度和压力,在高压和低温的环境下将样品快速冷冻,并通过切片获得薄片样品,可以有效地保持样品的原始结构和形态, 这种制备方法在透射电镜研究中具有重要的应用价值 。

2.高压冷冻切片的优点和缺点
高压冷冻切片是一种制样方法,其优点在于能够保留材料样品的原始结构和形态,该方法的历史可以追溯到20世纪60年代,当时科学家们开始尝试使用高压冷冻技术来制备生物样品的切片, 随着技术的发展,高压冷冻切片被广泛应用于材料科学领域,特别是透射电镜研究中 。
高压冷冻切片的主要优点之一是提供了更好的样品质量,传统制样方法如机械切割和离子薄化可能会导致样品的变形、伪像和伪相等问题,而高压冷冻切片能够减少这些不良影响,通过迅速将样品冷冻至极低温,并在冷冻状态下进行切割,可以固定样品的结构,避免了变形和伪像的产生,这样,研究者可以更准确地观察和分析样品的微观结构和组织。
此外,高压冷冻切片还能够保留样品中的溶剂和溶质分布,在传统的切片制备过程中,溶剂和溶质可能会被挥发或扩散,导致样品中的局部成分分布发生变化,而高压冷冻切片能够在非常短的时间内冻结样品,从而减少了溶质扩散的可能性,确保了样品中的组分保持原始状态,这对于材料的相变行为研究和微观成分分析非常重要。
然而,高压冷冻切片也存在一些局限性和挑战,首先,该方法需要使用专用的高压冷冻设备和样品固定装置,增加了实验的复杂性和成本,其次,由于高压冷冻切片需要在极低温下进行,样品制备过程中可能会受到温度梯度的影响,导致样品的不均匀冻结和切割,这可能会对观察和分析结果的准确性造成一定的影响,此外,高压冷冻切片的制备过程也需要较长的时间,限制了样品制备的效率和产量。
